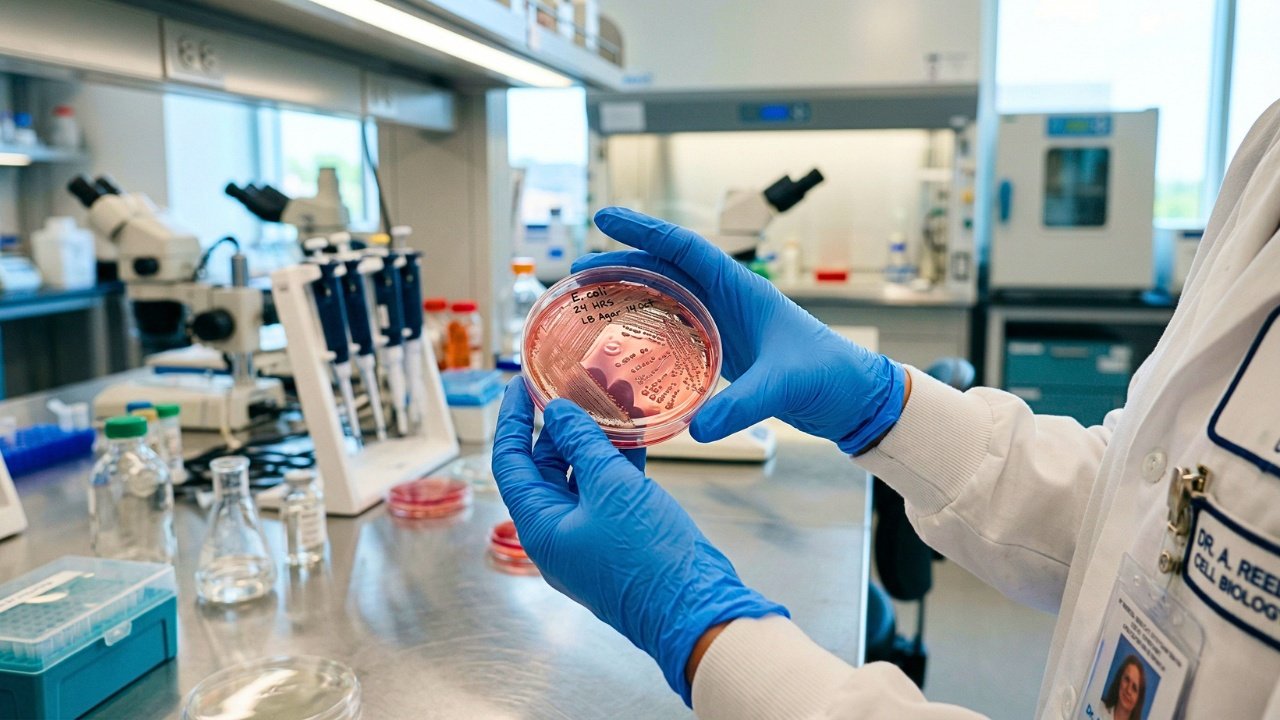
Células cancerígenas

A palavra câncer costuma causar apreensão imediata. No entanto, a biologia mostra uma realidade muito mais pragmática. É provável que você e boa parte dos adultos saudáveis já abriguem células cancerígenas microscópicas neste exato momento. Isso parece alarmante à primeira vista, mas muda a forma como encaramos a doença. O objetivo prático deixa de ser a tentativa de viver num ambiente perfeitamente limpo para evitar a mutação inicial e passa a ser impedir a progressão dessas células.
O longo relógio biológico das células cancerígenas
Pense na matemática do crescimento celular. Uma célula sofre mutação, divide-se em duas, depois em quatro. São necessárias cerca de 30 dessas duplicações sucessivas para chegar a 1 bilhão de células. Esse volume equivale a um tumor de cerca de 1 centímetro, que costuma ser o limite mínimo de detecção de uma mamografia padrão. O detalhe é que uma única duplicação celular pode levar de 50 a 1.000 dias. Isso indica que o diagnóstico de um câncer de mama aos 60 anos costuma ser o estágio tardio de uma divisão celular que começou décadas antes. Um tumor ovariano diagnosticado aos 60 anos, por exemplo, provavelmente iniciou o seu processo quando a paciente ainda era adolescente. Nós temos um período de tempo longo para intervir.
Iniciação e promoção: Controlando o desenvolvimento do câncer
Na medicina do estilo de vida, compreendemos o desenvolvimento da doença em duas fases principais. A iniciação ocorre quando o DNA sofre a mutação, um evento geralmente irreversível. Depois vem a promoção, que é a fase de crescimento ativo. É nesta segunda etapa que você assume o controle do seu ambiente biológico. Uma pessoa pode ter iniciado uma mutação genética aos 20 anos ao consumir carnes curadas com frequência. O que determina se essa célula vai proliferar é o estado inflamatório e metabólico do corpo hoje. Se você não fornecer um ambiente propício, o aglomerado de células mutantes pode passar a vida inteira estagnado.
Microtumores ocultos: O que as autópsias revelam
Estudos anatômicos mostram resultados muito esclarecedores. Cerca de 30% dos homens na casa dos 30 anos já apresentam câncer de próstata incipiente. Mais de um terço das mulheres na faixa dos 40 anos possui tumores microscópicos nas mamas. A lógica funcional é quase idêntica à da aterosclerose, onde vemos a formação de placas de gordura nas artérias de adultos jovens aos 20 anos de idade. O estilo de vida atua como um tratamento precoce para processos celulares que já estão em andamento. No Japão tradicional, os homens apresentavam uma prevalência de microtumores de próstata semelhante à dos americanos. A diferença é que a mortalidade entre os japoneses era cerca de 40 vezes menor. Eles morriam com o câncer, não em decorrência dele. A incidência agressiva só aumentou quando a dieta local incorporou o padrão ocidentalizado rico em produtos animais.
Como o corpo bloqueia o crescimento do tumor rapidamente
Há um estudo da Universidade da Califórnia que ilustra como o corpo pode se tornar hostil à progressão do tumor de forma rápida. Os pesquisadores instruíram um grupo de mulheres a seguir uma dieta baseada em plantas integrais, aliada a exercícios regulares por apenas duas semanas. Eles coletaram o sangue dessas pacientes antes e depois da intervenção. Em laboratório, os cientistas pingaram o soro sanguíneo sobre culturas de células de câncer de mama. O sangue coletado após os 14 dias reduziu a taxa de crescimento das células doentes em 12%. Além disso, a apoptose, que é a morte celular programada, aumentou em quase 25%. A fisiologia humana responde quase em tempo real.
O tratamento contra células cancerígenas começa no seu prato
O que a saúde pública chama de prevenção é, na realidade clínica, um tratamento contínuo. Você não precisa esperar por exames alterados para agir, pois a bioquímica do seu sangue se altera a cada refeição. A decisão de comer de forma adequada não exige um planejamento longo ou resoluções de ano novo. O ambiente celular muda com o que você coloca no prato hoje à noite. O sistema imunológico tem a capacidade natural de lidar com células anômalas. Você só precisa fornecer o substrato metabólico adequado para que ele faça o trabalho.